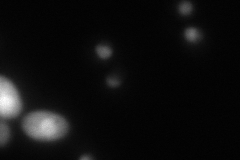
YOR140W

View description
Transcriptional repressor and activator; involved in repression of flocculation-related genes, and activation of stress responsive genes; negatively regulated by cAMP-dependent protein kinase A subunit Tpk2p
Localization:
Intensity:
Fold change:
Significance:
-
C’ GFP library in SD

nucleus35.65 -
N' NOP1pr-GFP in SD

nucleus,nucleolus53.0524 -
N' TEF2pr-mCherry in SD
nucleus38.4859 -
N' NATIVEpr-GFP in SD

nucleus27.1793 -
N' TEF2pr-VC and Cyto-VN in SD

#N/A0 -
C’ GFP library in SD+DTT

nucleus28.340.79No -
C’ GFP library in SD+H2O2

nucleus36.571.02No -
C’ GFP library in Starvation Media

nucleus32.30.9No -
C’ GFP library on the background of Pup2-DaMP

nucleus -
C’ GFP library on the background of CCT mutant

nucleus39.81221.1166No
